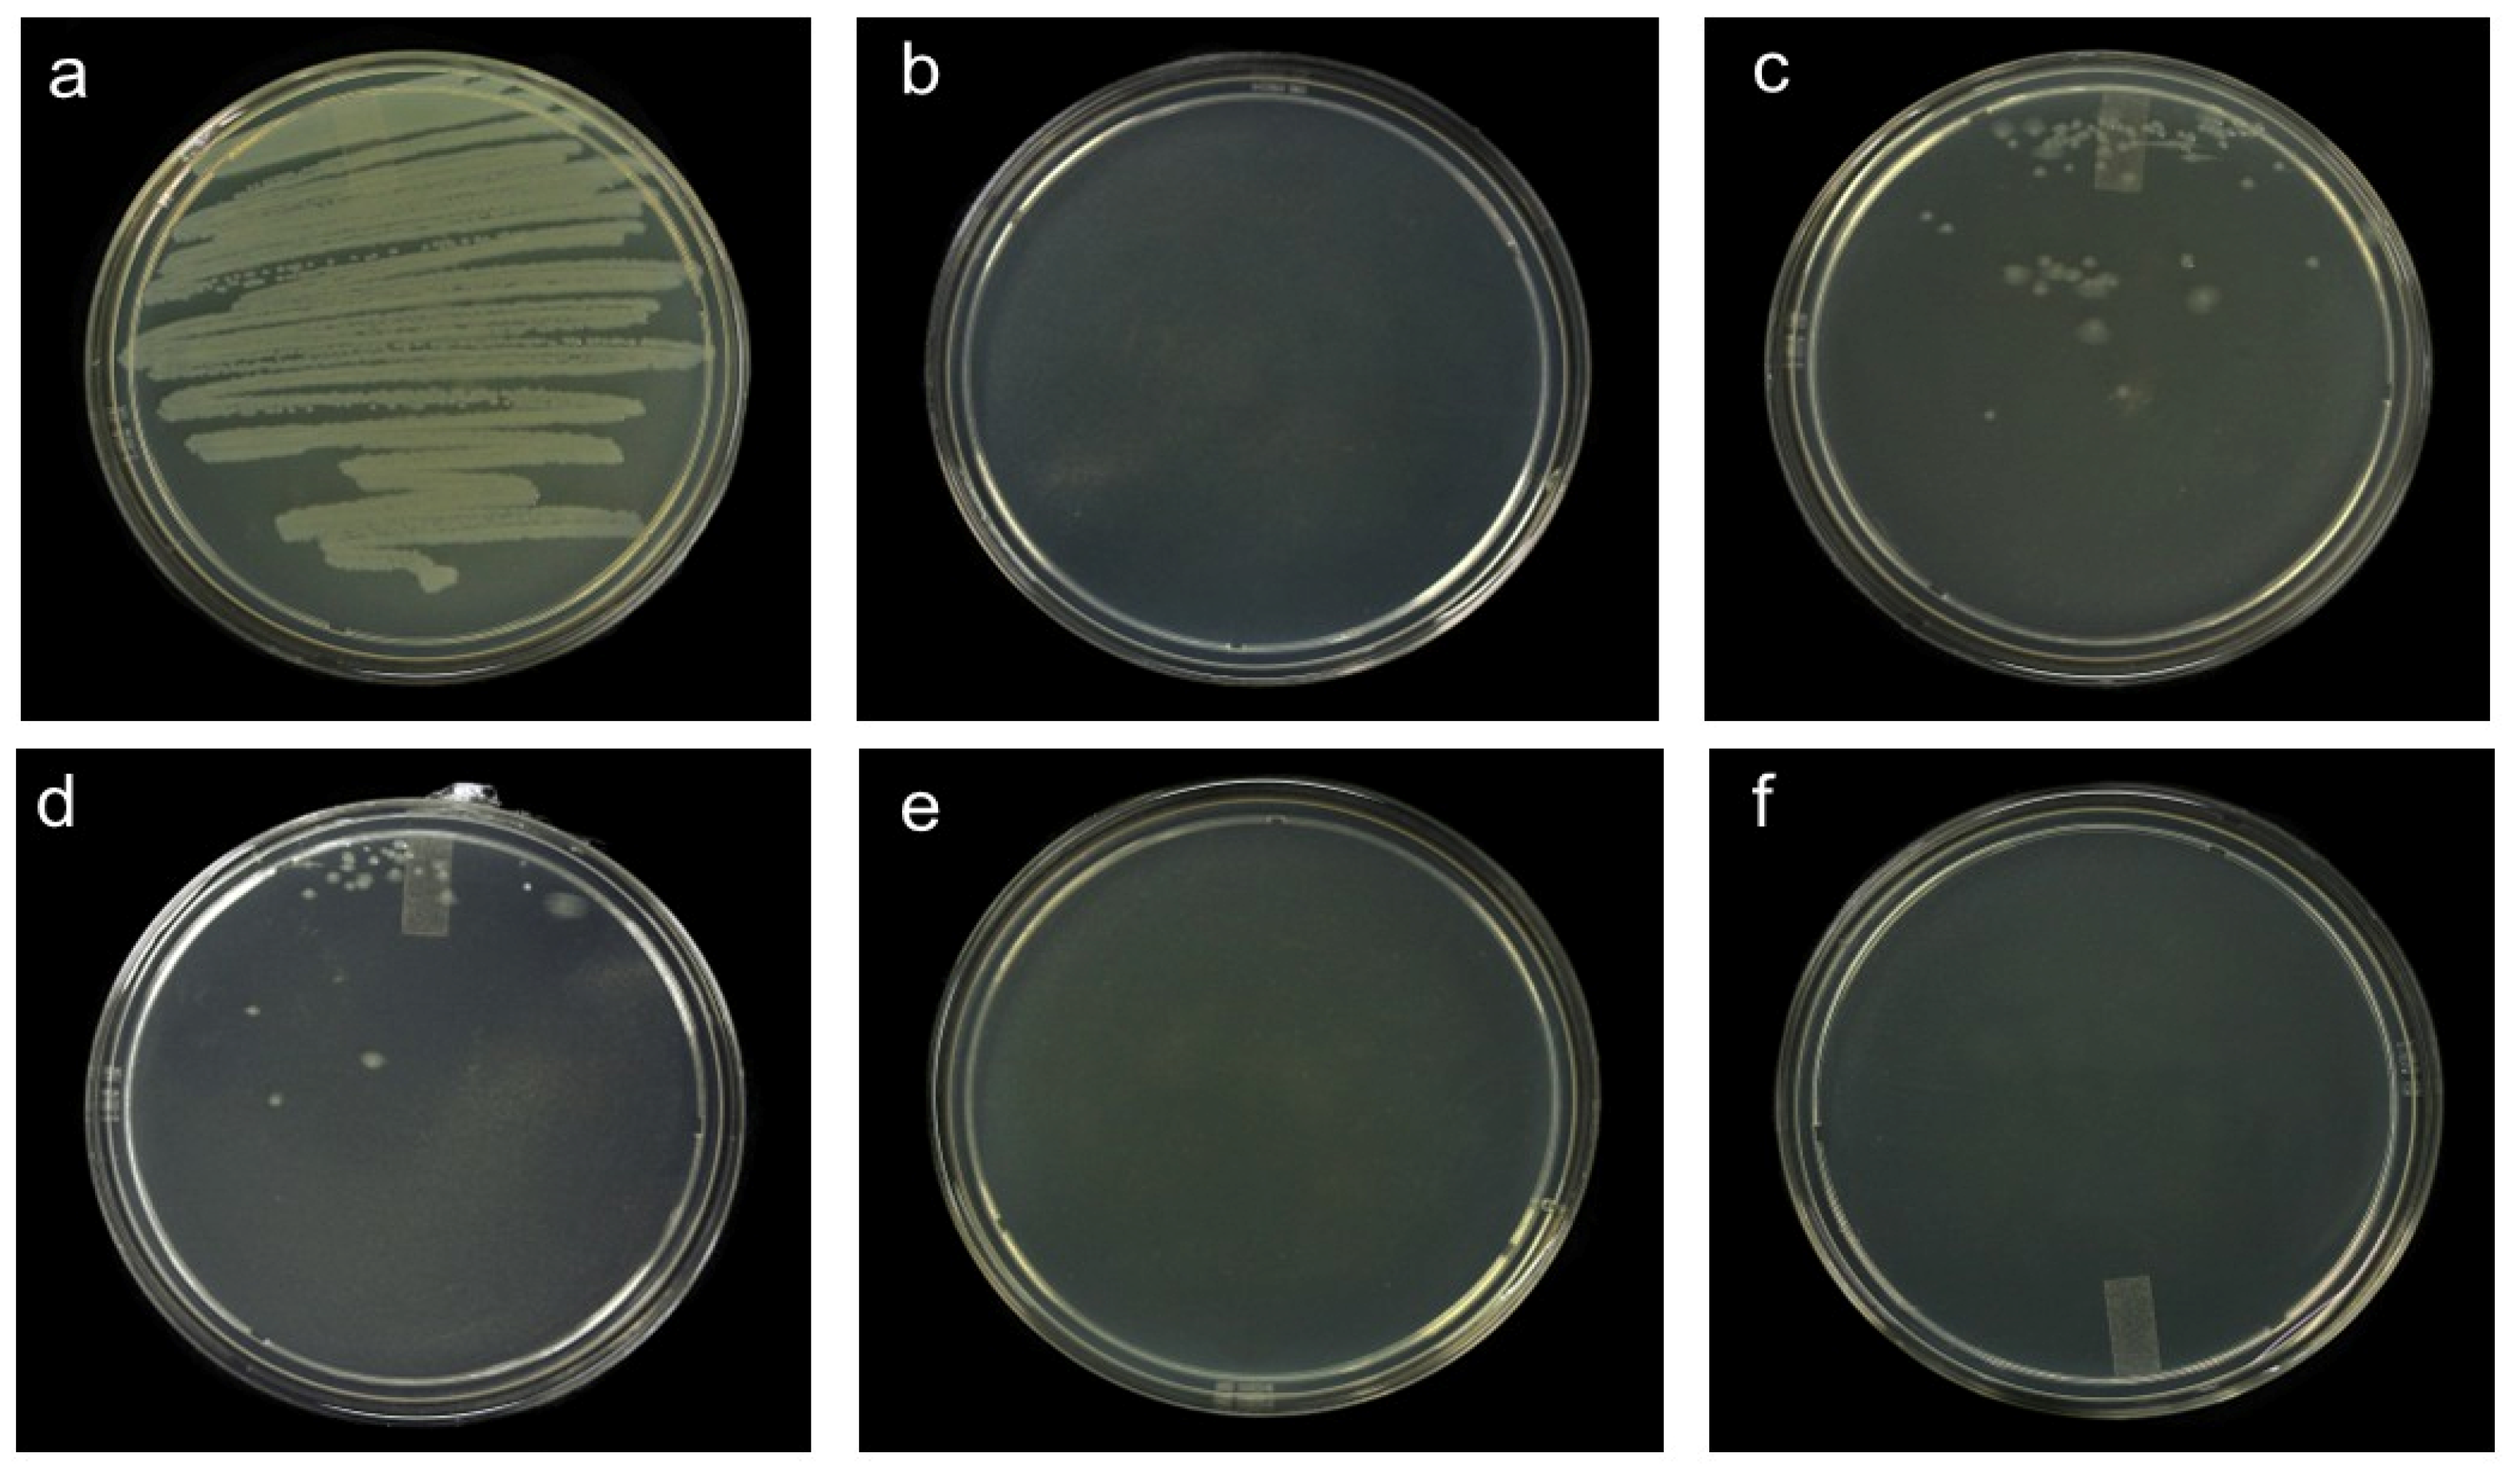
Horticulturae 11 00907 g003

Effect of Nanoparticles on the Development of Bacterial Speck in Tomato (Solanum lycopersicum L.) and Chili Variegation (Capsicum annuum L.)
Abstract
1. Introduction
2. Materials and Methods
2.1. Plant Material
2.2. Growth Kinetics
2.3. Minimum Inhibitory Concentration (MIC)
2.4. Minimum Lethal Concentration (MLC)
2.5. Nanoparticles Application
2.6. Pathogens Inoculation
2.7. Disease Severity
2.8. Dry Weight
2.9. Statistical Analysis
3. Results
3.1. Pathosystem One
3.1.1. Growth Kinetics of Pseudomonas syringae pv. tomato
3.1.2. Minimum Inhibitory Concentration (MIC) and Minimum Lethal Concentration (MLC)
3.1.3. Symptoms, Lesion Count, and Severity
3.1.4. Plant Height and Dry Weight
3.2. Pathosystem Two
3.2.1. Symptom Progression (Area Under the Disease Progression Curve) and Severity
3.2.2. Plant Height and Dry Weight
4. Discussion
4.1. Pathosystem One
4.2. Pathosystem Two
5. Conclusions
Author Contributions
Funding
Data Availability Statement
Acknowledgments
Conflicts of Interest
References
- FAO. Agricultural Production Statistics 2010–2023; FAO: Rome, Italy, 2024. [Google Scholar]
- FAO. FAOSTAT: Statistical Database. Available online: https://www.fao.org/faostat/en/ (accessed on 9 June 2025).
- Griffin, K.; Gambley, C.; Brown, P.; Li, Y. Copper-tolerance in Pseudomonas syringae pv. tomato and Xanthomonas spp. and the control of diseases associated with these pathogens in tomato and pepper. A systematic literature review. Crop Prot. 2017, 96, 144–150. [Google Scholar] [CrossRef]
- El-Fatah, B.E.S.A.; Imran, M.; Abo-Elyousr, K.A.M.; Mahmoud, A.F. Isolation of Pseudomonas syringae pv. tomato strains causing bacterial speck disease of tomato and marker-based monitoring for their virulence. Mol. Biol. Rep. 2023, 50, 4917–4930. [Google Scholar] [CrossRef] [PubMed]
- Camacho-Tapia, M.; Rojas-Martínez, R.I.; Zavaleta-Mejía, E.; Hernández-Deheza, M.G.; Carrillo-Salazar, J.A.; Rebollar-Alviter, A.; Ochoa-Martínez, D.L. Aetiology of Chili Pepper Variegation from Yurecuaro, Mexico. J. Plant Pathol. 2011, 93, 331–335. [Google Scholar]
- Velásquez-Valle, R.; Reveles-Torres, L.R.; Mena-Covarrubias, J.; Salas-Muñoz, S.; Mauricio-Castillo, J.A. Outbreak of Candidatus Liberibacter solanacearum in Dried Chile Pepper in Durango, Mexico. Agrofaz 2014, 14, 93–104. [Google Scholar]
- Boholm, M.; Arvidsson, R. A Definition Framework for the Terms Nanomaterial and Nanoparticle. Nanoethics 2016, 10, 25–40. [Google Scholar] [CrossRef]
- Joudeh, N.; Linke, D. Nanoparticle Classification, Physicochemical Properties, Characterization, and Applications: A Comprehensive Review for Biologists. J. Nanobiotechnol. 2022, 20, 262. [Google Scholar] [CrossRef]
- Khan, Y.; Sadia, H.; Zeeshan, S.; Shah, A.; Khan, M.N.; Shah, A.A.; Ullah, N.; Ullah, M.F.; Bibi, H.; Bafakeeh, O.T.; et al. Classsification, Synthetic, and Characterization Approaches to Nanoparticles, and Their Applications in Various Fields of Nanotechnology: A Review. Catalysts 2022, 12, 1386. [Google Scholar] [CrossRef]
- Abdelkhalek, A.; Al-Askar, A.A. Green synthesized ZnO nanoparticles mediated by Mentha spicata extract induce plant systemic resistance against Tobacco Mosaic Virus. Appl. Sci. 2020, 10, 5504. [Google Scholar] [CrossRef]
- Morones, J.R.; Elechiguerra, J.L.; Camacho, A.; Holt, K.; Kouri, J.B.; Ramírez, J.T.; Yacaman, M.J. The Bactericidal Effect of Silver Nanoparticles. Nanotechnology 2005, 16, 2346–2353. [Google Scholar] [CrossRef]
- Kumar, A.; Choudhary, A.; Kaur, H.; Guha, S.; Mehta, S.; Husen, A. Potential Applications of Engineered Nanoparticles in Plant Disease Management: A Critical Update. Chemosphere 2022, 295, 133798. [Google Scholar] [CrossRef]
- Dutta, P.; Kumari, A.; Mahanta, M.; Upamanya, G.K.; Heisnam, P.; Borua, S.; Kaman, P.K.; Mishra, A.K.; Mallik, M.; Muthukrishnan, G.; et al. Nanotechnological Approaches for Management of Soil-Borne Plant Pathogens. Front. Plant Sci. 2023, 14, 1136233. [Google Scholar] [CrossRef] [PubMed]
- Stewart, E.J. Growing unculturable bacteria. J. Bacteriol. 2012, 194, 4151–4160. [Google Scholar] [CrossRef]
- Lambert, R.; Pearson, J. Effect of Storage Conditions on the Quality Characteristics of Onion. J. Appl. Microbiol. 2000, 88, 784–790. [Google Scholar] [CrossRef]
- Green, L.H.; Goldman, E. Practical Handbook of Microbiology; Elsevier: Boca Raton, FL, USA, 2021. [Google Scholar]
- Bharti, D.B.; Bharati, A.V. Synthesis of ZnO Nanoparticles Using a Hydrothermal Method and a Study Its Optical Activity. Luminescence 2016, 32, 317–320. [Google Scholar] [CrossRef]
- Madden, L.V.; Hughes, G.; van den Bosch, F. The Study of Plant Disease Epidemics; APS Press: St. Paul, MN, USA, 2007. [Google Scholar]
- Valenzuela, M.; Fuentes, B.; Alfaro, J.F.; Galvez, E.; Salinas, A.; Besoain, X.; Seeger, M. First report of bacterial speck caused by Pseudomonas syringae pv. tomato race 1 affecting tomato in different regions of Chile. Plant Dis. 2022, 106, 1979. [Google Scholar] [CrossRef]
- El-Shetehy, M.; Moradi, A.; Maceroni, M.; Reinhardt, D.; Petri-Fink, A.; Rothen-Rutishauser, B.; Mauch, F.; Schwab, F. Silica nanoparticles enhance disease resistance in Arabidopsis plants. Nat. Nanotechnol. 2021, 16, 344–353. [Google Scholar] [CrossRef]
- Ijaz, M.; Lv, L.; Ahmed, T.; Noman, M.; Manan, A.; Ijaz, R.; Hafeez, R.; Shahid, M.S.; Wang, D.; Ondrasek, G.; et al. Immunomodulating melatonin-decorated silica nanoparticles suppress bacterial wilt (Ralstonia solanacearum) in tomato (Solanum lycopersicum L.) through fine-tuning of oxidative signaling and rhizosphere bacterial community. J. Nanobiotechnol. 2024, 22, 617. [Google Scholar] [CrossRef]
- Parveen, A.; Siddiqui, Z.A. Impact of Silicon Dioxide Nanoparticles on Growth, Photosynthetic Pigments, Proline, Activities of Defense Enzymes and Some Bacterial and Fungal Pathogens of Tomato. Vegetos 2022, 35, 83–93. [Google Scholar] [CrossRef]
- Elsharkawy, M.; Derbalah, A.; Hamza, A.; El-Shaer, A. Zinc oxide nanostructures as a control strategy of bacterial speck of tomato caused by Pseudomonas syringae in Egypt. Environ. Sci. Pollut. Res. 2020, 27, 19049–19057. [Google Scholar] [CrossRef]
- Parveen, A.; Siddiqui, Z.A. Zinc Oxide Nanoparticles Affect Growth, Photosynthetic Pigments, Proline Content and Bacterial and Fungal Diseases of Tomato. Arch. Phytopathol. Plant Prot. 2021, 54, 1519–1538. [Google Scholar] [CrossRef]
- Siddiqui, Z.A.; Khan, M.R.; Abd_Allah, E.F.; Parveen, A. Titanium dioxide and zinc oxide nanoparticles affect some bacterial diseases, and growth and physiological changes of beetroot. Int. J. Veg. Sci. 2019, 25, 409–430. [Google Scholar] [CrossRef]
- Orfei, B.; Scian, A.; Del Buono, D.; Paglialunga, M.; Tolisano, C.; Priolo, D.; Moretti, C.; Buonaurio, R. Biogenic zinc oxide nanoparticles protect tomato plants against Pseudomonas syringae pv. tomato. Horticulturae 2025, 11, 431. [Google Scholar] [CrossRef]
- Loera-Muro, A.; Contreras-Arvizu, G.I.; Palestino, G.; Hern, L.G.; Luis, P.; Daniel, L.; Figueroa, M.; Hern, L. Effect of zinc oxide nanorods on biofilms of different pathovars of Pseudomonas syringae. Mater. Lett. 2024, 376, 137334. [Google Scholar] [CrossRef]
- Yang, C.; Zhong, Y.; Powell, C.A.; Doud, M.S.; Duan, Y.; Huang, Y.; Zhang, M. Antimicrobial Compounds Effective against Candidatus Liberibacter Asiaticus Discovered via Graft-Based Assay in Citrus. Sci. Rep. 2018, 8, 17288. [Google Scholar] [CrossRef]
- Velmurugan, P.; Lee, S.M.; Iydroose, M.; Lee, K.J.; Oh, B.T. Pine Cone-Mediated Green Synthesis of Silver Nanoparticles and Their Antibacterial Activity against Agricultural Pathogens. Appl. Microbiol. Biotechnol. 2013, 97, 361–368. [Google Scholar] [CrossRef] [PubMed]
- Das, A.; Deb, C.; Lahiri, S.; Kundu, S. Antimicrobial Effect of Green Synthesized Silver Nanoparticles on Plant Pathogenic Bacteria Pseudomonas syringae pv. tomato. J. Mycopathol. Res. 2023, 61, 2583–6315. [Google Scholar]
- Khan, A.U.; Khan, M.; Khan, M.M. Antifungal and antibacterial assay by silver nanoparticles synthesized from aqueous leaf extract of Trigonella foenum-graecum. Bionanoscience 2019, 9, 597–602. [Google Scholar] [CrossRef]
- Iqbal, M.; Raja, N.I.; Khan, S.A.; Ali, A.; Hanif, A.; Hussain, M.; Anwar, T.; Qureshi, H.; Saeed, M.; Rauf, A. Evaluation of Green Synthesized Silver Nanoparticles against Bacterial Pathogenic Strains of Plants. Pak. J. Bot. 2023, 55, 1967–1972. [Google Scholar] [CrossRef] [PubMed]
- Manosalva, N.; Tortella, G.; Cristina Diez, M.; Schalchli, H.; Seabra, A.B.; Durán, N.; Rubilar, O. Green Synthesis of Silver Nanoparticles: Effect of Synthesis Reaction Parameters on Antimicrobial Activity. World J. Microbiol. Biotechnol. 2019, 35, 88. [Google Scholar] [CrossRef]
- Shahryari, F.; Rabiei, Z.; Sadighian, S. Antibacterial activity of synthesized silver nanoparticles by sumac aqueous extract and silver-chitosan nanocomposite against Pseudomonas syringae pv. syringae. J. Plant Pathol. 2020, 102, 469–475. [Google Scholar] [CrossRef]
- Khan, M.A.; Dzimitrowicz, A.; Prusinski, M.; Motyka-Pomagruk, A.; Jamroz, P.; Cyganowski, P.; Łojkowska, E.; Sledz, W.; Pohl, P. Coffee-mediated synthesis of silver nanoparticles showing antibacterial properties against economically important phytopathogens from the genus Pseudomonas. Colloids Surf. A Physicochem. Eng. Asp. 2025, 718, 136802. [Google Scholar] [CrossRef]
- Fan, G.; Xiao, Q.; Li, Q.; Xia, Y.; Feng, H.; Ma, X.; Cai, L.; Sun, X. Antimicrobial mechanisms of ZnO nanoparticles to phytopathogen Pseudomonas syringae: Damage of cell envelope, suppression of metabolism, biofilm and motility, and stimulation of stomatal immunity on host plant. Pestic. Biochem. Physiol. 2023, 194, 105455. [Google Scholar] [CrossRef]
- Danish, M.; Shahid, M.; Ahamad, L.; Raees, K.; Atef Hatamleh, A.; Al-Dosary, M.A.; Mohamed, A.; Al-Wasel, Y.A.; Singh, U.B.; Danish, S. Nano-pesticidal potential of Cassia fistula leaf synthesized silver nanoparticles (Ag@CfL-NPs): Deciphering the phytopathogenic inhibition and growth augmentation in Solanum lycopersicum. Front. Microbiol. 2022, 13, 985852. [Google Scholar] [CrossRef]
- Paul, K.; Großkinsky, D.K.; Vass, I.; Roitsch, T. Silver nanoparticles affect Arabidopsis thaliana leaf tissue integrity and suppress Pseudomonas syringae infection symptoms in a dose-dependent manner. Bionanoscience 2022, 12, 332–338. [Google Scholar] [CrossRef]
- Jiang, L.; Xiang, S.; Lv, X.; Wang, X.; Li, F.; Liu, W.; Liu, C.; Ran, M.; Huang, J.; Xu, X.; et al. Biosynthesized silver nanoparticles inhibit Pseudomonas syringae pv. tabaci by directly destroying bacteria and inducing plant resistance in Nicotiana benthamiana. Phytopathol. Res. 2022, 4, 48. [Google Scholar] [CrossRef]
- Sondi, I.; Salopek-Sondi, B. Silver nanoparticles as antimicrobial agent: A case study on E. coli as a model for gram-negative bacteria. Colloid Interface Sci. 2004, 275, 177–182. [Google Scholar] [CrossRef] [PubMed]
- Wahab, M.A.; Luming, L.; Matin, M.A.; Karim, M.R.; Aijaz, M.O.; Alharbi, H.F.; Abdala, A.; Haque, R. Silver Micro-Nanoparticle-Based Nanoarchitectures: Synthesis Routes, Biomedical Applications, and Mechanisms of Action. Polymers 2021, 13, 2870. [Google Scholar] [CrossRef]
- Hancharova, M.; Halicka-Stępień, K.; Dupla, A.; Lesiak, A.; Sołoducho, J.; Cabaj, J. Antimicrobial Activity of Metal-Based Nanoparticles: A Mini-Review. BioMetals 2024, 37, 773–801. [Google Scholar] [CrossRef]
- Casals, E.; Gusta, M.F.; Bastus, N.; Rello, J.; Puntes, V. Silver Nanoparticles and Antibiotics: A Promising Synergistic Approach to Multidrug-Resistant Infections. Microorganisms 2025, 13, 952. [Google Scholar] [CrossRef] [PubMed]
- Kashyap, D.; Siddiqui, Z.A. Effect of silicon dioxide nanoparticles and Rhizobium leguminosarum alone and in combination on the growth and bacterial blight disease complex of pea caused by Meloidogyne incognita and Pseudomonas syringae pv. pisi. Arch. Phytopathol. Plant Prot. 2021, 54, 499–515. [Google Scholar] [CrossRef]
- Awad-Allah, E.F.A.; Shams, A.H.M.; Helaly, A.A. Suppression of Bacterial Leaf Spot by Green Synthesized Silica Nanoparticles and Antagonistic Yeast Improves Growth, Productivity and Quality of Sweet Pepper. Plants 2021, 10, 1689. [Google Scholar] [CrossRef]
- Wang, L.; Pan, T.; Gao, X.; An, J.; Ning, C.; Li, S.; Cai, K. Silica nanoparticles activate defense responses by reducing reactive oxygen species under Ralstonia solanacearum infection in tomato plants. NanoImpact 2022, 28, 100418. [Google Scholar] [CrossRef]
- Thounaojam, T.C.; Meetei, T.T.; Devi, Y.B.; Panda, S.K.; Upadhyaya, H. Zinc Oxide Nanoparticles (ZnO-NPs): A Promising Nanoparticle in Renovating Plant Science. Acta Physiol. Plant. 2021, 43, 136. [Google Scholar] [CrossRef]
- Levy, J.G.; Gross, R.; Mendoza-Herrera, A.; Tang, X.; Babilonia, K.; Shan, L.; Kuhl, J.C.; Dibble, M.S.; Xiao, F.; Tamborindeguy, C. Lso-HPE1, an Effector of “Candidatus Liberibacter Solanacearum”, Can Repress Plant Immune Response. Phytopathology 2020, 110, 648–655. [Google Scholar] [CrossRef]
- Merfa, M.V.; Pérez-López, E.; Naranjo, E.; Jain, M.; Gabriel, D.W.; De La Fuente, L. Progress and Obstacles in Culturing ‘Candidatus Liberibacter Asiaticus’, the Bacterium Associated with Huanglongbing. Phytopathology 2019, 109, 1092–1101. [Google Scholar] [CrossRef]
- Larue, C.; Castillo-Michel, H.; Sobanska, S.; Cécillon, L.; Bureau, S.; Barthès, V.; Ouerdane, L.; Carrière, M.; Sarret, G. Foliar exposure of the crop Lactuca sativa to silver nanoparticles: Evidence for internalization and changes in Ag speciation. J. Hazard. Mater. 2014, 264, 98–106. [Google Scholar] [CrossRef]
- Li, C.C.; Dang, F.; Li, M.; Zhu, M.; Zhong, H.; Hintelmann, H.; Zhou, D.M. Effects of Exposure Pathways on the Accumulation and Phytotoxicity of Silver Nanoparticles in Soybean and Rice. Nanotoxicology 2017, 11, 699–709. [Google Scholar] [CrossRef] [PubMed]
- Wu, J.; Wang, G.; Vijver, M.G.; Bosker, T.; Peijnenburg, W.J.G.M. Foliar versus Root Exposure of AgNPs to Lettuce: Phytotoxicity, Antioxidant Responses and Internal Translocation. Environ. Pollut. 2020, 261, 114117. [Google Scholar] [CrossRef] [PubMed]
- Wang, W.N.; Tarafdar, J.C.; Biswas, P. Nanoparticle Synthesis and Delivery by an Aerosol Route for Watermelon Plant Foliar Uptake. J. Nanoparticle Res. 2013, 15, 1417. [Google Scholar] [CrossRef]
- Raliya, R.; Nair, R.; Chavalmane, S.; Wang, W.N.; Biswas, P. Mechanistic evaluation of translocation and physiological impact of titanium dioxide and zinc oxide nanoparticles on the tomato (Solanum lycopersicum L.) plant. Metallomics 2015, 7, 1584–1594. [Google Scholar] [CrossRef]
- Cantu, J.M.; Ye, Y.; Hernandez-Viezcas, J.A.; Zuverza-Mena, N.; White, J.C.; Gardea-Torresdey, J.L. Tomato Fruit Nutritional Quality Is Altered by the Foliar Application of Various Metal Oxide Nanomaterials. Nanomaterials 2022, 12, 2349. [Google Scholar] [CrossRef] [PubMed]
- Hussain, H.I.; Yi, Z.; Rookes, J.E.; Kong, L.X.; Cahill, D.M. Mesoporous Silica Nanoparticles as a Biomolecule Delivery Vehicle in Plants. J. Nanoparticle Res. 2013, 15, 1676. [Google Scholar] [CrossRef]
- Zhao, P.; Cao, L.; Ma, D.; Zhou, Z.; Huang, Q.; Pan, C. Translocation, Distribution and Degradation of Prochloraz-Loaded Mesoporous Silica Nanoparticles in Cucumber Plants. Nanoscale 2018, 10, 1798–1806. [Google Scholar] [CrossRef] [PubMed]
- Francis, D.V.; Abdalla, A.K.; Mahakham, W.; Sarmah, A.K.; Ahmed, Z.F.R. Interaction of Plants and Metal Nanoparticles: Exploring Its Molecular Mechanisms for Sustainable Agriculture and Crop Improvement. Environ. Int. 2024, 190, 108859. [Google Scholar] [CrossRef] [PubMed]
- Naranjo, E.; Merfa, M.V.; Santra, S.; Ozcan, A.; Johnson, E.; Cobine, P.A.; De La Fuente, L. Zinkicide Is a ZnO-Based Nanoformulation with Bactericidal Activity against Liberibacter crescens in Batch Cultures and in Microfluidic Chambers Simulating Plant Vascular Systems. Appl. Environ. Microbiol. 2020, 86, e00788-20. [Google Scholar] [CrossRef]

| Value | Symptoms |
|---|---|
| 0 | Asymptomatic plants |
| 1 | 1/3 chlorosis (upper third) |
| 2 | 2/3 chlorosis and reduced leaf area (upper third) |
| 3 | Stunting, shortened internodes, flower bud abortion |
| 4 | Generalized chlorosis and wilting |
| 5 | Up to 50% defoliation |
| 6 | More than 50% of defoliation and plant death |
| Treatment | UFC/mL |
|---|---|
| Positive control | a |
| ZnONPs | b |
| AgNPs | ± 296.76 b |
Disclaimer/Publisher’s Note: The statements, opinions and data contained in all publications are solely those of the individual author(s) and contributor(s) and not of MDPI and/or the editor(s). MDPI and/or the editor(s) disclaim responsibility for any injury to people or property resulting from any ideas, methods, instructions or products referred to in the content. |
© 2025 by the authors. Licensee MDPI, Basel, Switzerland. This article is an open access article distributed under the terms and conditions of the Creative Commons Attribution (CC BY) license (https://creativecommons.org/licenses/by/4.0/).
Share and Cite
Ruiz-Ramirez, E.A.; Ochoa-Martínez, D.L.; Velázquez-Juárez, G.; Rojas-Martinez, R.I.; Zuñiga-Mayo, V.M. Effect of Nanoparticles on the Development of Bacterial Speck in Tomato (Solanum lycopersicum L.) and Chili Variegation (Capsicum annuum L.). Horticulturae 2025, 11, 907. https://doi.org/10.3390/horticulturae11080907
Ruiz-Ramirez EA, Ochoa-Martínez DL, Velázquez-Juárez G, Rojas-Martinez RI, Zuñiga-Mayo VM. Effect of Nanoparticles on the Development of Bacterial Speck in Tomato (Solanum lycopersicum L.) and Chili Variegation (Capsicum annuum L.). Horticulturae. 2025; 11(8):907. https://doi.org/10.3390/horticulturae11080907
Chicago/Turabian StyleRuiz-Ramirez, Edgar Alejandro, Daniel Leobardo Ochoa-Martínez, Gilberto Velázquez-Juárez, Reyna Isabel Rojas-Martinez, and Victor Manuel Zuñiga-Mayo. 2025. "Effect of Nanoparticles on the Development of Bacterial Speck in Tomato (Solanum lycopersicum L.) and Chili Variegation (Capsicum annuum L.)" Horticulturae 11, no. 8: 907. https://doi.org/10.3390/horticulturae11080907
APA StyleRuiz-Ramirez, E. A., Ochoa-Martínez, D. L., Velázquez-Juárez, G., Rojas-Martinez, R. I., & Zuñiga-Mayo, V. M. (2025). Effect of Nanoparticles on the Development of Bacterial Speck in Tomato (Solanum lycopersicum L.) and Chili Variegation (Capsicum annuum L.). Horticulturae, 11(8), 907. https://doi.org/10.3390/horticulturae11080907

